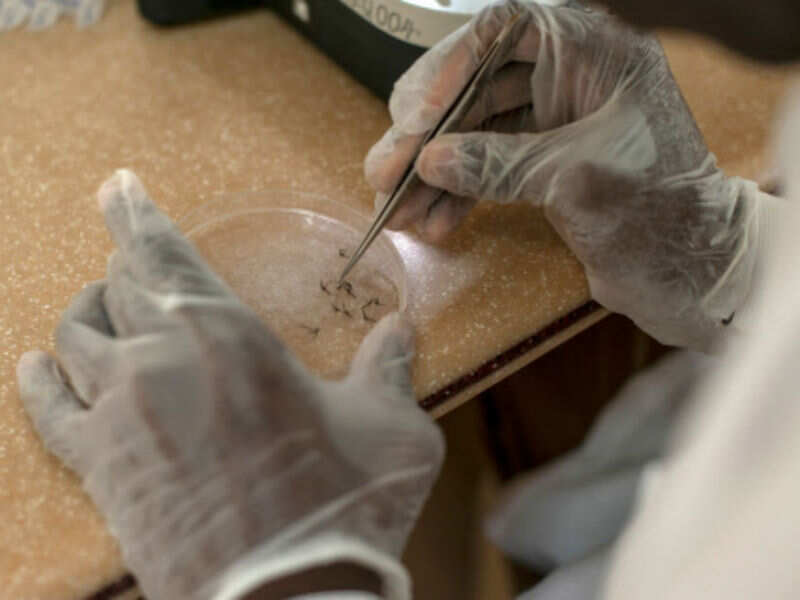

The handle, or receptor, is located on cells that build cartilage, muscle and bone. Joints are filled with such cells, which helps explain patient's painful symptoms, according to the findings published in the journal Nature.
By creating decoy handles, the researchers at Washington University School of Medicine in the US showed that they could reduce chikungunya infection and signs of arthritis.
"We now know how chikungunya gets into cells, and we may have found a way to block the infection," said Michael S Diamond, a professor at Washington University School of Medicine.
"If the virus cannot get into the cell, it is unable to replicate and cause infection and disease," Diamond said.
There are no specific treatments or vaccines for chikungunya and related viruses, known as arthritogenic alphaviruses, according to researchers.
Doctors simply recommend rest, fluids and over-the-counter pain relievers such as acetaminophen or ibuprofen, they said.
Diamond and colleagues identified the protein on cells that chikungunya virus latches onto.
The protein is called Mxra8, and it is needed for chikungunya to invade both human and mouse cells, the researchers found.
Additional experiments showed that not just chikungunya but its arthritis-causing relatives - Mayaro, Ross River, O'nyongnyong and Barmah Forest viruses - require the protein to get into cells.
Since chikungunya uses Mxra8 protein as a handle to open a door into cells, the researchers tested whether preventing the virus from grabbing that handle could reduce infection.
They deluged the virus with decoy handles, reasoning that chikungunya would grab the decoy and be locked out of cells.
Only the few individual viruses that lucked onto a true handle could infect cells, so the overall infection rate - and signs of arthritis - would fall, researchers said.
A day after infection, the level of virus in the mice's ankles and calf muscles was between tenfold and a hundredfold lower in the animals that had been treated with Mxra8 proteins or blocking antibodies than those that received placebo, and the numbers remained lower over the next two days.
In addition, three days after treatment, the mice that had received the protein exhibited much less swelling in their ankles than those that received the placebo.
The results suggest that a compound that blocks the virus from attaching to Mxra8 on the surface of cells could prevent or reduce arthritis.